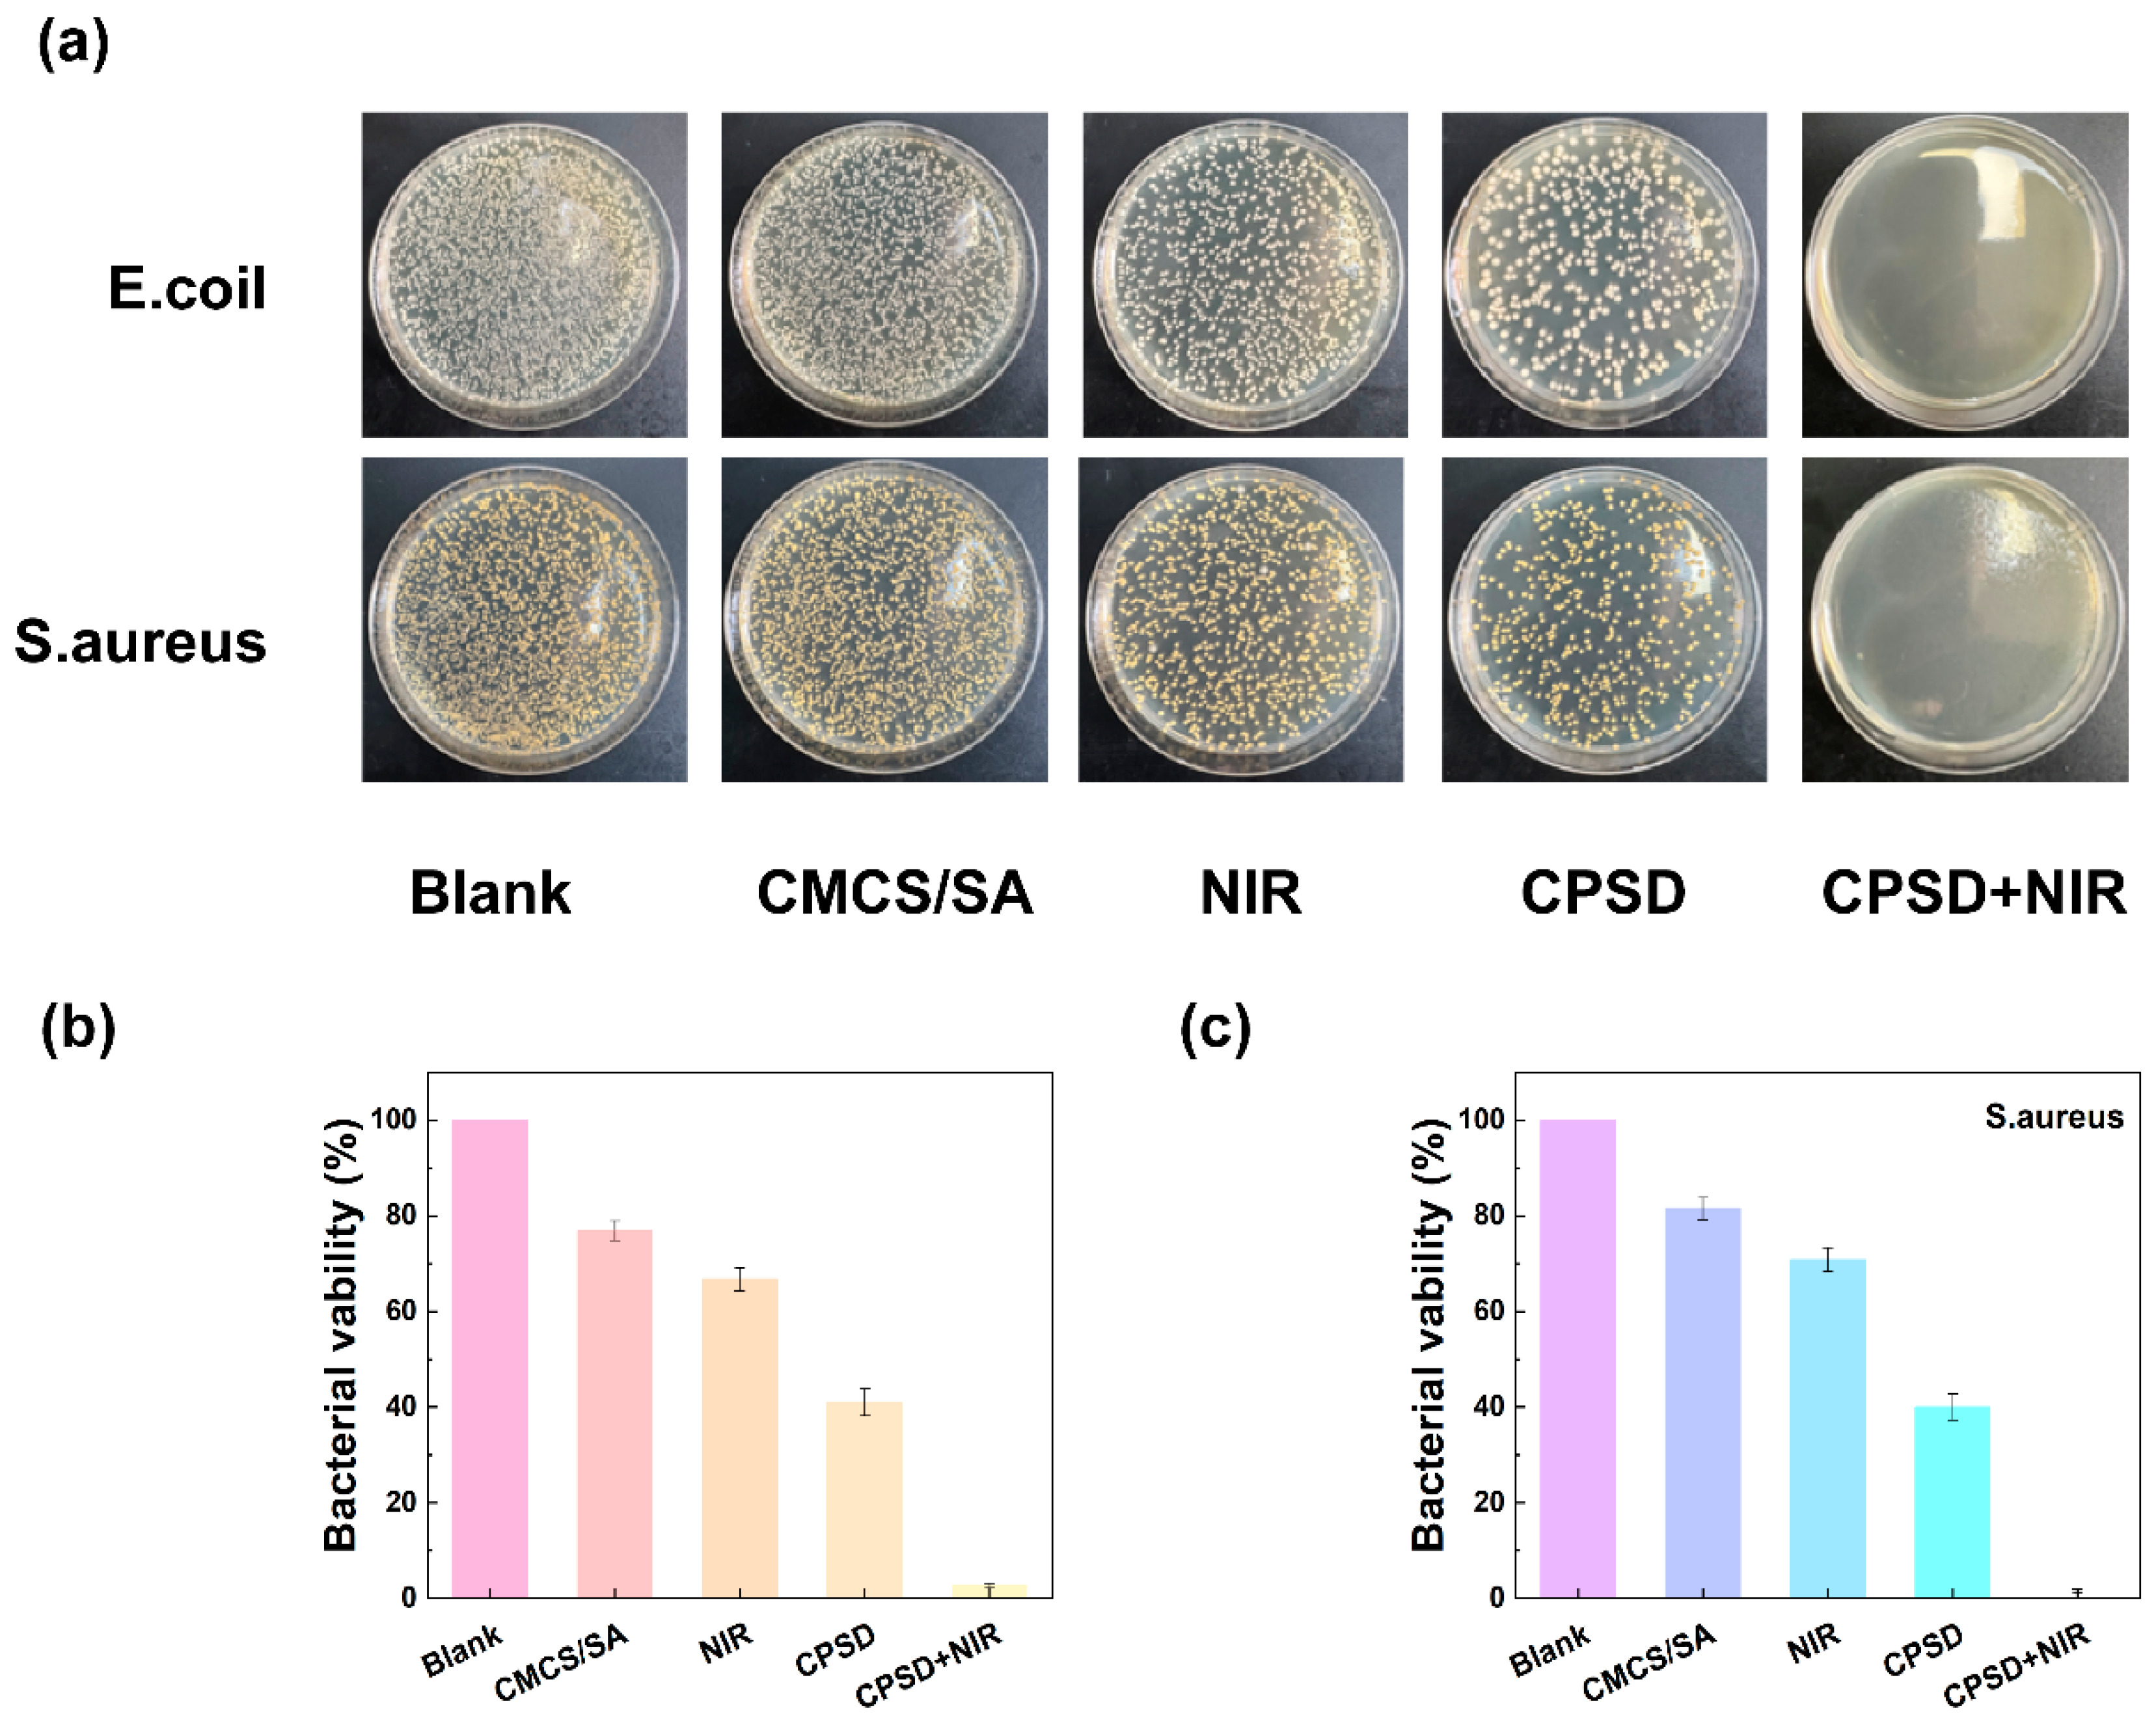
Sensors 25 06727 g004

Biointegrated Conductive Hydrogel for Real-Time Motion Sensing in Exoskeleton-Assisted Lower-Limb Rehabilitation
Highlights
- A multifunctional CPSD composite hydrogel was developed by integrating conductive PEDOT:PSS and dopamine-functionalized alginate into a carboxymethyl chitosan matrix.
- The hydrogel exhibits strong antioxidant, antibacterial, and biocompatible properties with stable adhesion under dynamic exoskeleton-assisted rehabilitation.
- The CPSD hydrogel enables simultaneous wound protection and real-time lower-limb motion sensing.
- This work provides a foundation for closed-loop wearable rehabilitation systems that combine bioelectronic sensing with therapeutic functionality.
Abstract
1. Introduction
2. Materials and Methods
2.1. Materials
2.2. Preparation and Characterization of Composite Hydrogels
2.2.1. Preparation of CP and SD Nanoparticles
2.2.2. Preparation of CMCS/SA Hydrogels
2.2.3. Preparation of CPSD Hydrogels
2.2.4. Characterization of CPSD Hydrogels
2.3. Swelling and Degradation of Composite Hydrogels
2.4. In Vitro Antibacterial Performance of CPSD Hydrogels
2.5. Cell Viability Assay of CPSD Hydrogels
2.5.1. CCK8 Assay of CPSD Hydrogels
2.5.2. Hemolysis Assay of CPSD Hydrogels
2.5.3. Live/Dead Cell Staining of CPSD Hydrogels
2.6. Antioxidant Activity Evaluation of CPSD Hydrogels
2.7. Adhesion Test of Composite Hydrogels
2.8. WVTR Test of Composite Hydrogels
2.9. Real Sensing Applications: Biosignal Acquisition, Processing, and Agreement Analysis
2.10. Statistical Analysis
3. Results
3.1. Synthesis and Characterization of CPSD Composite Hydrogel
3.2. Fundamental Properties of CPSD Hydrogel
3.2.1. The Swelling, Degradation and WVTR Properties of CPSD
3.2.2. The Rheological and Mechanical Properties of CPSD
3.3. Antioxidant Properties of CPSD Composite Hydrogel
3.4. Antibacterial Properties of CPSD Composite Hydrogel
3.5. Biocompatibility Performance of CPSD Composite Hydrogel
3.6. Application of CPSD Composite Hydrogel Lower Limb Exoskeleton
4. Discussion
5. Conclusions
Supplementary Materials
Author Contributions
Funding
Informed Consent Statement
Data Availability Statement
Acknowledgments
Conflicts of Interest
References
- Tang, H.; Li, Y.; Zhang, J.W.; Zhang, D.; Yu, H. Design and Optimization of a Novel Sagittal-Plane Knee Exoskeleton with Remote-Center-of-Motion Mechanism. Mech. Mach. Theory 2024, 194, 105570. [Google Scholar] [CrossRef]
- Wang, T.; Zhang, B.; Liu, C.; Liu, T.; Han, Y.; Wang, S.; Ferreira, J.P.; Dong, W.; Zhang, X. A Review on the Rehabilitation Exoskeletons for the Lower Limbs of the Elderly and the Disabled. Electronics 2022, 11, 388. [Google Scholar] [CrossRef]
- Kim, J.-H.; Han, J.W.; Kim, D.Y.; Baek, Y.S. Design of a Walking Assistance Lower Limb Exoskeleton for Paraplegic Patients and Hardware Validation Using CoP. Int. J. Adv. Robot. Syst. 2013, 10, 113. [Google Scholar] [CrossRef]
- Li, W.; Liu, K.; Li, C.; Sun, Z.; Liu, S.; Gu, J. Development and Evaluation of a Wearable Lower Limb Rehabilitation Robot. J. Bionic Eng. 2022, 19, 688–699. [Google Scholar] [CrossRef]
- Hu, B.; Su, Y.; Zou, H.; Sun, T.; Yang, J.; Yu, H. Disturbance Rejection Speed Control Based on Linear Extended State Observer for Isokinetic Muscle Strength Training System. IEEE Trans. Autom. Sci. Eng. 2023, 20, 1962–1971. [Google Scholar] [CrossRef]
- Küçüktabak, E.B.; Wen, Y.; Kim, S.J.; Short, M.R.; Ludvig, D.; Hargrove, L.; Perreault, E.J.; Lynch, K.M.; Pons, J.L. Haptic Transparency and Interaction Force Control for a Lower Limb Exoskeleton. IEEE Trans. Robot. 2024, 40, 1842–1859. [Google Scholar] [CrossRef]
- Li, X.; Xiao, Y.; He, C.; Hu, B.; Yu, H. A Gait Simulation and Evaluation System for Hip Disarticulation Prostheses. IEEE Trans. Autom. Sci. Eng. 2021, 18, 448–457. [Google Scholar] [CrossRef]
- Song, D.; Ye, G.; Zhao, Y.; Zhang, Y.; Hou, X.; Liu, N. An All-in-One, Bioderived, Air-Permeable, and Sweat-Stable MXene Epidermal Electrode for Muscle Theranostics. ACS Nano 2022, 16, 17168–17178. [Google Scholar] [CrossRef]
- Sedighi, P.; Li, X.; Tavakoli, M. EMG-Based Intention Detection Using Deep Learning for Shared Control in Upper-Limb Assistive Exoskeletons. IEEE Robot. Autom. Lett. 2024, 9, 41–48. [Google Scholar] [CrossRef]
- Shi, P.; Zhang, X.; Li, W.; Yu, H. Improving the Robustness and Adaptability of sEMG-Based Pattern Recognition Using Deep Domain Adaptation. IEEE J. Biomed. Health Inform. 2022, 26, 5450–5460. [Google Scholar] [CrossRef]
- Rosales-Luengas, Y.; Espinosa-Espejel, K.I.; Lopéz-Gutiérrez, R.; Salazar, S.; Lozano, R. Lower Limb Exoskeleton for Rehabilitation with Flexible Joints and Movement Routines Commanded by Electromyography and Baropodometry Sensors. Sensors 2023, 23, 5252. [Google Scholar] [CrossRef]
- Aghchehli, E.; Kyranou, I.; Dyson, M.; Nazarpour, K. Digital Sensing Systems for Electromyography. IEEE Trans. Neural Syst. Rehabil. Eng. 2024, 32, 2826–2834. [Google Scholar] [CrossRef]
- Zhang, W.; Xu, L.; Zhao, M.; Ma, Y.; Zheng, T.; Shi, L. Stretchable, Self-Healing and Adhesive Sodium Alginate-Based Composite Hydrogels as Wearable Strain Sensors for Expansion–Contraction Motion Monitoring. Soft Matter 2022, 18, 1644–1652. [Google Scholar] [CrossRef] [PubMed]
- Hu, J.; Yang, L.; Yang, P.; Jiang, S.; Liu, X.; Li, Y. Polydopamine Free Radical Scavengers. Biomater. Sci. 2020, 8, 4940–4950. [Google Scholar] [CrossRef] [PubMed]
- Roubert Martinez, S.; Le Floch, P.; Liu, J.; Howe, R.D. Pure Conducting Polymer Hydrogels Increase Signal-to-Noise of Cutaneous Electrodes by Lowering Skin Interface Impedance. Adv. Healthc. Mater. 2023, 12, 2202661. [Google Scholar] [CrossRef]
- Li, M.; Wang, S.; Li, Y.; Meng, X.; Wei, Y.; Wang, Y.; Chen, Y.; Xiao, Y.; Cheng, Y. An Integrated All-Natural Conductive Supramolecular Hydrogel Wearable Biosensor with Enhanced Biocompatibility and Antibacterial Properties. ACS Appl. Mater. Interfaces 2024, 16, 51618–51629. [Google Scholar] [CrossRef]
- Shirzadi, E.; Huynh, M.; GhavamiNejad, P.; Zheng, H.; Saini, A.; Bakhshandeh, F.; Keyvani, F.; Mantaila, D.; Rahman, F.A.; Quadrilatero, J.; et al. A PEDOT:PSS-Based Composite Hydrogel as a Versatile Electrode for Wearable Microneedle Sensing Platforms. Adv. Sens. Res. 2024, 3, 2300122. [Google Scholar] [CrossRef]
- Shen, Y.; Zhang, Z.; Chen, X.; He, C. Tissue-Adhesive, Antibacterial, Naturally-Derived Polymer Hydrogels as Wound Dressings for Infected and Chronic Wound Healing. J. Polym. Sci. 2024, 62, 2320–2339. [Google Scholar] [CrossRef]
- Li, Y.; Zhang, X.; Tan, S.; Li, Z.; Sun, J.; Li, Y.; Xie, Z.; Li, Z.; Han, F.; Liu, Y. Design strategies of PEDOT:PSS-based conductive hydrogels and their applications in health monitoring. Polymers 2025, 17, 1192. [Google Scholar] [CrossRef]
- Rescio, G.; Sciurti, E.; Giampetruzzi, L.; Carluccio, A.M.; Francioso, L.; Leone, A. Preliminary Study on Wearable Smart Socks with Hydrogel Electrodes for Surface Electromyography-Based Muscle Activity Assessment. Sensors 2025, 25, 1618. [Google Scholar] [CrossRef]
- Psarrou, M.; Mitraki, A.; Vamvakaki, M.; Kokotidou, C. Stimuli-Responsive Polysaccharide Hydrogels and Their Composites for Wound Healing Applications. Polymers 2023, 15, 986. [Google Scholar] [CrossRef]
- Wang, L.; Zhao, Z.; Dong, J.; Li, D.; Dong, W.; Li, H.; Zhou, Y.; Liu, Q.; Deng, B. Mussel-Inspired Multifunctional Hydrogels with Adhesive, Self-Healing, Antioxidative, and Antibacterial Activity for Wound Healing. ACS Appl. Mater. Interfaces 2023, 15, 16515–16525. [Google Scholar] [CrossRef]
- Rahman, M.S.; Shon, A.; Joseph, R.; Pavlov, A.; Stefanov, A.; Namkoong, M.; Guo, H.; Bui, D.; Master, R.; Sharma, A.; et al. Soft, Stretchable Conductive Hydrogels for High-Performance Electronic Implants. Sci. Adv. 2025, 11, eads4415. [Google Scholar] [CrossRef]
- Chung, T.W.; Yang, J.; Akaike, T.; Cho, K.Y.; Nah, J.W.; Kim, S.I.; Cho, C.S. Preparation of Alginate/Galactosylated Chitosan Scaffold for Hepatocyte Attachment. Biomaterials 2002, 23, 2827–2834. [Google Scholar] [CrossRef]
- Jonkman, M.F.; Molenaar, I.; Nieuwenhuis, P.; Bruin, P.; Pennings, A.J. New Method to Assess the Water Vapour Permeance of Wound Coverings. Biomaterials 1988, 9, 263–267. [Google Scholar] [CrossRef]
- Gasperini, G.; Gaffuri, M.; Guanziroli, E.; Goffredo, M.; Puornajaf, S.; Galafate, D.; Russo, E.; Filoni, S.; Franceschini, M.; Molteni, F. Recovery of Gait Function with a Wearable Powered Exoskeleton in Sub-Acute Stroke Patients Using SEMG for Fine Tuning: Preliminary Results. Ann. Phys. Rehabil. Med. 2018, 61, e93. [Google Scholar] [CrossRef]
- Fan, P.; Fan, H.; Wang, S. From Emerging Modalities to Advanced Applications of Hydrogel Piezoelectrics Based on Chitosan, Gelatin and Related Biological Macromolecules: A Review. Int. J. Biol. Macromol. 2024, 262, 129691. [Google Scholar] [CrossRef] [PubMed]
- Liao, L.; Zhang, J.; Ding, J.; Xu, C.; Zhu, L.; Hou, Y.; Li, S.; Zhang, J.; Wei, B.; Wang, H. Adhesive, Biocompatible, Antibacterial, and Degradable Collagen-Based Conductive Hydrogel as Strain Sensor for Human Motion Monitoring. Molecules 2024, 29, 5728. [Google Scholar] [CrossRef] [PubMed]
- Wang, L.; Zhang, Z.; Cao, J.; Zheng, W.; Zhao, Q.; Chen, W.; Xu, X.; Luo, X.; Liu, Q.; Liu, X.; et al. Low Hysteresis and Fatigue-Resistant Polyvinyl Alcohol/Activated Charcoal Hydrogel Strain Sensor for Long-Term Stable Plant Growth Monitoring. Polymers 2023, 15, 90. [Google Scholar] [CrossRef] [PubMed]
- Jodko-Piórecka, K.; Sikora, B.; Kluzek, M.; Przybylski, P.; Litwinienko, G. Antiradical Activity of Dopamine, L-DOPA, Adrenaline, and Noradrenaline in Water/Methanol and in Liposomal Systems. J. Org. Chem. 2022, 87, 1791–1804. [Google Scholar] [CrossRef]
- Alegre-Requena, J.V.; Häring, M.; Herrera, R.P.; Díaz, D.D. Regulatory Parameters of Self-Healing Alginate Hydrogel Networks Prepared via Mussel-Inspired Dynamic Chemistry. New J. Chem. 2016, 40, 8493–8501. [Google Scholar] [CrossRef]
- Wang, X.; Jiang, Z.; Shi, J.; Zhang, C.; Zhang, W.; Wu, H. Dopamine-Modified Alginate Beads Reinforced by Cross-Linking via Titanium Coordination or Self-Polymerization and Its Application in Enzyme Immobilization. Ind. Eng. Chem. Res. 2013, 52, 14828–14836. [Google Scholar] [CrossRef]
- Ho, C.-C.; Ding, S.-J. The pH-Controlled Nanoparticles Size of Polydopamine for Anti-Cancer Drug Delivery. J. Mater. Sci. Mater. Med. 2013, 24, 2381–2390. [Google Scholar] [CrossRef] [PubMed]
- Cao, J.; Zhang, Z.; Wang, L.; Lin, T.; Li, H.; Zhao, Q.; Wang, H.; Liu, X.; Yang, H.; Lu, B. An Adhesive, Highly Stretchable and Low-Hysteresis Alginate-Based Conductive Hydrogel Strain Sensing System for Motion Capture. Int. J. Biol. Macromol. 2024, 281, 136581. [Google Scholar] [CrossRef]
- Tang, L.; Wu, S.; Qu, J.; Gong, L.; Tang, J. A Review of Conductive Hydrogel Used in Flexible Strain Sensor. Materials 2020, 13, 3947. [Google Scholar] [CrossRef]
- Li, M.; Pu, J.; Cao, Q.; Zhao, W.; Gao, Y.; Meng, T.; Chen, J.; Guan, C. Recent Advances in Hydrogel-Based Flexible Strain Sensors for Harsh Environment Applications. Chem. Sci. 2024, 15, 17799–17822. [Google Scholar] [CrossRef]
- Liu, T.; Feng, Z.; Li, Z.; Lin, Z.; Chen, L.; Li, B.; Chen, Z.; Wu, Z.; Zeng, J.; Zhang, J.; et al. Carboxymethyl Chitosan/Sodium Alginate Hydrogels with Polydopamine Coatings as Promising Dressings for Eliminating Biofilm and Multidrug-Resistant Bacteria Induced Wound Healing. Int. J. Biol. Macromol. 2023, 225, 923–937. [Google Scholar] [CrossRef]
- Gao, N.; Yu, J.; Tian, Q.; Shi, J.; Zhang, M.; Chen, S.; Zang, L. Application of PEDOT:PSS and Its Composites in Electrochemical and Electronic Chemosensors. Chemosensors 2021, 9, 79. [Google Scholar] [CrossRef]
- Salomäki, M.; Marttila, L.; Kivelä, H.; Ouvinen, T.; Lukkari, J. Effects of pH and Oxidants on the First Steps of Polydopamine Formation: A Thermodynamic Approach. J. Phys. Chem. B 2018, 122, 6314–6327. [Google Scholar] [CrossRef]
- Bu, Y.; Xu, H.-X.; Li, X.; Xu, W.-J.; Yin, Y.; Dai, H.; Wang, X.; Huang, Z.-J.; Xu, P.-H. A Conductive Sodium Alginate and Carboxymethyl Chitosan Hydrogel Doped with Polypyrrole for Peripheral Nerve Regeneration. RSC Adv. 2018, 8, 10806–10817. [Google Scholar] [CrossRef] [PubMed]
- Yaron, J.R.; Gosangi, M.; Pallod, S.; Rege, K. In Situ Light-Activated Materials for Skin Wound Healing and Repair: A Narrative Review. Bioeng. Transl. Med. 2024, 9, e10637. [Google Scholar] [CrossRef]
- Shang, W.; Huang, R.; Lin, Y.; Liang, F.; Yin, M.; Lu, X.-P.; Wu, X.; Gao, F. Characterizing sEMG Changes with Muscle Fatigue for Lower-Extremity Prostheses and Exoskeletons Control. In Proceedings of the 2024 46th Annual International Conference of the IEEE Engineering in Medicine and Biology Society (EMBC), Orlando, FL, USA, 15–19 July 2024; pp. 1–6. [Google Scholar]
- Wang, C.; Guo, Z.; Duan, S.; He, B.; Yuan, Y.; Wu, X. A Real-Time Stability Control Method Through sEMG Interface for Lower Extremity Rehabilitation Exoskeletons. Front. Neurosci. 2021, 15, 645374. [Google Scholar] [CrossRef]
- Wang, X.; Zhang, C.; Yu, Z.; Deng, C. Decoding of Lower Limb Continuous Movement Intention from Multi-Channel sEMG and Design of Adaptive Exoskeleton Controller. Biomed. Signal Process. Control 2024, 94, 106245. [Google Scholar] [CrossRef]
- Qin, Y.; Wei, E.; Cui, C.; Xie, J. High Tensile, Antibacterial, and Conductive Hydrogel Sensor with Multiple Cross-Linked Networks Based on PVA/Sodium Alginate/Zinc Oxide. ACS Omega 2024, 9, 16851–16859. [Google Scholar] [CrossRef] [PubMed]
- Chen, D.; Zhao, X.; Gao, H.; Ren, G.; Luo, J.; Wang, H.; Zha, C.; Yang, K.; Jia, P. High-Strength, Conductive, Antifouling, and Antibacterial Hydrogels for Wearable Strain Sensors. ACS Biomater. Sci. Eng. 2022, 8, 2624–2635. [Google Scholar] [CrossRef]
- Sun, H.; Dong, Z.; Kou, X.; Zhao, Q.; Shi, L.; Ma, Y.; Ma, Y. Herbal molecule-mediated dual network hydrogels with adhesive and antibacterial properties for strain and pressure sensing. RSC Adv. 2023, 13, 5762–5769. [Google Scholar] [CrossRef]
- Lam, E.; Alizadeh-Meghrazi, M.; Schlums, A.; Eskandarian, L.; Mahnam, A.; Moineau, B.; Popovic, M.R. Exploring textile-based electrode materials for electromyography smart garments. J. Rehabil. Assist. Technol. Eng. 2022, 9, 20556683211061995. [Google Scholar] [CrossRef]
- Kim, S.; Lee, S.; Jeong, W. EMG Measurement with Textile-Based Electrodes in Different Electrode Sizes and Clothing Pressures for Smart Clothing Design Optimization. Polymers 2020, 12, 2406. [Google Scholar] [CrossRef] [PubMed]
- Tyuftin, A.A.; Pecorini, F.; Zanardi, E.; Kerry, J.P. Parameters Affecting the Water Vapour Permeability of Gelatin Films as Evaluated by the Infrared Detecting Method ASTM F1249. Sustainability 2022, 14, 9018. [Google Scholar] [CrossRef]

Disclaimer/Publisher’s Note: The statements, opinions and data contained in all publications are solely those of the individual author(s) and contributor(s) and not of MDPI and/or the editor(s). MDPI and/or the editor(s) disclaim responsibility for any injury to people or property resulting from any ideas, methods, instructions or products referred to in the content. |
© 2025 by the authors. Licensee MDPI, Basel, Switzerland. This article is an open access article distributed under the terms and conditions of the Creative Commons Attribution (CC BY) license (https://creativecommons.org/licenses/by/4.0/).
Share and Cite
Li, M.; Li, H.; Su, Y.; Tong, R.K.-Y.; Yu, H. Biointegrated Conductive Hydrogel for Real-Time Motion Sensing in Exoskeleton-Assisted Lower-Limb Rehabilitation. Sensors 2025, 25, 6727. https://doi.org/10.3390/s25216727
Li M, Li H, Su Y, Tong RK-Y, Yu H. Biointegrated Conductive Hydrogel for Real-Time Motion Sensing in Exoskeleton-Assisted Lower-Limb Rehabilitation. Sensors. 2025; 25(21):6727. https://doi.org/10.3390/s25216727
Chicago/Turabian StyleLi, Ming, Hui Li, Yujie Su, Raymond Kai-Yu Tong, and Hongliu Yu. 2025. "Biointegrated Conductive Hydrogel for Real-Time Motion Sensing in Exoskeleton-Assisted Lower-Limb Rehabilitation" Sensors 25, no. 21: 6727. https://doi.org/10.3390/s25216727
APA StyleLi, M., Li, H., Su, Y., Tong, R. K.-Y., & Yu, H. (2025). Biointegrated Conductive Hydrogel for Real-Time Motion Sensing in Exoskeleton-Assisted Lower-Limb Rehabilitation. Sensors, 25(21), 6727. https://doi.org/10.3390/s25216727

